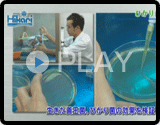
山崎研究所について

- キョーリン
- キョーリン動画館

摂餌動画
金魚
-
きんぎょのえさ 5つの力プロモーション ショートver(3:49)

キンギョ

この動画の商品紹介
きんぎょのえさ 5つの力
-
きんぎょのえさ 5つの力プロモーション ロングver(5:06)

キンギョ

この動画の商品紹介
きんぎょのえさ 5つの力
-

キンギョ

この動画の商品紹介
ひかりどんぶりキンギョ
-

東錦、ランチュウ

この動画の商品紹介
オランダゴールド
-

ピンポンパール、ランチュウ

この動画の商品紹介
咲ひかり金魚
熱帯魚・海水魚
-

熱帯魚、グッピー、キンギョ、メダカ

この動画の商品紹介
特設ページへ
-

熱帯魚、グッピー、キンギョ、メダカ

この動画の商品紹介
特設ページへ
-

グッピー、カラシン

この動画の商品紹介
クレストフリーク バイオバイツ
-

コリドラス、ローチ

この動画の商品紹介
クレストフリーク コリビッツ
-

プレコ

この動画の商品紹介
クレストフリーク ペコルテ
-
-
ビーシュリンプ
-

この動画の商品紹介
クレストフリーク シャビオ
-
-
-
金魚、メダカ、熱帯魚
-

この動画の商品紹介
ルスタクス
-
-

アロワナ、オスカー

この動画の商品紹介
カーニバル
-

ナンヨウハギ、キイロハギ、カクレクマノミ

この動画の商品紹介
ひかりプレミアム メガバイトレッド
-

プレコ

この動画の商品紹介
ひかりクレスト プレコ
-

ベタ

この動画の商品紹介
ひかりベタ
-

シクリッド

この動画の商品紹介
シクリッドバイオゴールド
-

グッピーなど

この動画の商品紹介
ひかりクレストグッピー
-

コリドラス、クラウンローチなど

この動画の商品紹介
ひかりクレストコリドラス
-

アロワナ

この動画の商品紹介
ひかりクレストビッグカーニバル
-

小型ナマズ類

この動画の商品紹介
ひかりクレストミニキャット
-

小型ナマズ類

この動画の商品紹介
ひかりクレストキャット
-

エンドリケリー、レッドテールキャット

この動画の商品紹介
ひかりクレストビッグキャット
-

ディスカス、エンゼルフィッシュ、ドワーフシクリッド

この動画の商品紹介
ひかりクレストディスカス
-

ディスカス、エンゼルフィッシュ、ドワーフシクリッド

この動画の商品紹介
バイブラバイツ
-

シクリッド類

この動画の商品紹介
ひかりシクリッドエクセル
-

コリドラス、カージナルテトラ

この動画の商品紹介
もぐもぐバスケット
-

金魚、鯉、エンゼルフィッシュなどの中型熱帯魚、グッピーなどの小型熱帯魚

この動画の商品紹介
ビタクリンアカムシ、ビタクリンアカムシ ミニキューブ、エコクリンアカムシ
メダカ・川魚
-

メダカ

この動画の商品紹介
メダカの舞(ブリード・ネクスト・コンプリート・スーパーオレンジ)、すくすくメダカ、教材メダカのエサ、メダカのエサ 産卵繁殖用
-

メダカ・金魚・熱帯魚などの稚魚

この動画の商品紹介
イージーブライン
-

メダカ・金魚

この動画の商品紹介
イージーグリーン
両生類・爬虫類
-

クレステッドゲッコー

この動画の商品紹介
クレスゾル
-

ヒョウモントカゲモドキ

この動画の商品紹介
レオパドライ
-

ヒョウモントカゲモドキ

この動画の商品紹介
レオパドライ
-

ヒョウモントカゲモドキ

この動画の商品紹介
レオパゲル
-

ヒョウモントカゲモドキ

この動画の商品紹介
レオパゲル
-

ヒョウモントカゲモドキ など

この動画の商品紹介
レオパゲル
-

フトアゴヒゲトカゲ

この動画の商品紹介
フトアゴドライ
-

フトアゴヒゲトカゲ

この動画の商品紹介
フトアゴゲル
-

ベルツノカエル

この動画の商品紹介
ひかりベルツノ
-

ベルツノカエル

この動画の商品紹介
ひかりベルツノ
-

ヘルマンリクガメ

この動画の商品紹介
マルベリックドライ 大粒
-

ヘルマンリクガメ

この動画の商品紹介
マルベリックドライ
-

ロシアリクガメ

この動画の商品紹介
リックゼリー
-

インドホシガメ

この動画の商品紹介
リックゼリー
-

ケヅメリクガメ

この動画の商品紹介
リックゼリー
-

コバルトツリー

この動画の商品紹介
モニタードライ
-
-
クレステッドゲッコー
-

この動画の商品紹介
クレスミックス
-
-

プロバグズ

この動画の商品紹介
プロバグズ
-
-
コオロギ
-

この動画の商品紹介
カルガット
-
小動物
鳥
-

インコ小~大型、文鳥、十姉妹、カナリヤ

この動画の商品紹介
キラピピ
-

インコ、十姉妹、文鳥、カナリヤなどの雛鳥

この動画の商品紹介
キラピピ ベビー
-

オカメインコの雛鳥

この動画の商品紹介
キラピピ ベビー
-

コザクラインコの雛鳥

この動画の商品紹介
キラピピ ベビー
-

十姉妹などのフィンチ

この動画の商品紹介
キラピピ フィンチ
-

白文鳥などのフィンチ

この動画の商品紹介
キラピピ フィンチ
-

桜文鳥などのフィンチ

この動画の商品紹介
キラピピ フィンチ
-

コザクラインコなどの小型インコ

この動画の商品紹介
キラピピ インコ小粒
-

ホオミドリアカオウロコインコなどの小型インコ

この動画の商品紹介
キラピピ インコ小粒
-

コザクラインコ ルチノーなどの小型インコ

この動画の商品紹介
キラピピ インコ小粒
-

オカメインコなどの中型インコ

この動画の商品紹介
キラピピ インコ中粒
-
オカメインコ+ホオミドリアカオウロコインコ 給餌風景(0:39)

オカメインコ、ホオミドリアカオウロコインコなどの中型インコ

この動画の商品紹介
キラピピ インコ中粒
-

オカメインコなどの中型インコ

この動画の商品紹介
キラピピ インコ中粒
-

オカメインコなどの中型インコ

この動画の商品紹介
キラピピ インコ中粒
-

ホオミドリアカオウロコインコなどの中型インコ

この動画の商品紹介
キラピピ インコ中粒
-

オカメインコなどの中型インコ

この動画の商品紹介
キラピピ インコ中粒
-

ホオミドリアカオウロコインコなどの大型インコ

この動画の商品紹介
キラピピ インコ大粒
-

ワカケホンセイインコなどの大型インコ

この動画の商品紹介
キラピピ インコ大粒
-

コオオハナインコモドキなどの大型インコ

この動画の商品紹介
キラピピ インコ大粒
-

コオオハナインコモドキなどの大型インコ

この動画の商品紹介
キラピピ インコ大粒
-

スグロシロハラインコなどの大型インコ

この動画の商品紹介
キラピピ インコ大粒
-
ホオミドリアカオウロコインコ パイナップル 給餌風景(0:27)

ホオミドリアカオウロコインコ パイナップルなどの大型インコ

この動画の商品紹介
キラピピ インコ大粒
-
ホオミドリアカオウロコインコ パイナップル 給餌風景(0:26)

ホオミドリアカオウロコインコ パイナップルなどの大型インコ

この動画の商品紹介
キラピピ インコ大粒
その他
-

レッドビーシュリンプ

この動画の商品紹介
ひかりエビ
観賞魚用器具
-

熱帯魚、グッピー、キンギョ、メダカ

この動画の商品紹介
水ごとネット
-

熱帯魚、グッピー、キンギョ、メダカなどの屋内用観賞魚

この動画の商品紹介
C-8000ヒューズ+

商品マメ知識
飼い方動画
-

-
はじめてメダカを飼うのに必要なこと、メダカの水槽の設置の方法、メダカのエサ(餌・飼料)の種類など。役立つ情報をまとめました。
この動画の商品紹介
メダカ・川魚用飼料
Hikari インタビュー「2度目の栄冠、Sレジェンドへの熱き思い」阪井養魚場 阪井健太郎氏
-

-
Hikari インタビュー「2度目の栄冠、Sレジェンドへの熱き思い」阪井養魚場 阪井健太郎氏(03:58)
第50回全日本錦鯉品評会で2度目の全体総合優勝を果たした「Sレジェンド」。「伝説」と呼ばれるほどの紅白を育て上げた、阪井養魚場・阪井健太郎社長にインタビューをさせていただきました。
この動画の商品紹介
咲ひかりシリーズ
Hikariリポート「Sレジェンドを探る」PART2
-

-
Hikariリポート「Sレジェンドを探る」PART2(22:03)
2016年11月 全日本愛鱗会国際品評会 全体総合優勝、2017年1月 全日本総合錦鯉品評会 大会総合優勝と、ほぼ満票で二冠を制した「Sレジェンド」。「伝説」と呼ばれるほどの紅白はいかにして生まれたか。生産者である、阪井養魚場 五代目当主 阪井 健太郎氏のロングインタビュー。
この動画の商品紹介
咲ひかりシリーズ
Hikariリポート「Sレジェンドを探る」PART1
-

-
Hikariリポート「Sレジェンドを探る」PART1(15:11)
2016年11月 全日本愛鱗会国際品評会 全体総合優勝、2017年1月 全日本総合錦鯉品評会 大会総合優勝と、ほぼ満票で二冠を制した「Sレジェンド」。「伝説」と呼ばれるほどの紅白はいかにして生まれたか。当時オーナーであった白坂大四郎氏に聞いてみた。
この動画の商品紹介
咲ひかりシリーズ
マイクロコーティング沈降速度試験
カーボンパック
-

-
大きな分子である黄ばみ分子や、小さな分子であるニオイ分子の両方を効率良く除去できます。
この動画の商品紹介
ひかりウェーブ カーボンパック
クレストカーニバル
-

-
口当たりの良さを持ちながら、水を汚さない保形性を両立しています。この特性は、キョーリン独自の製法により実現しました。
この動画の商品紹介
クレスト カーニバル、クレスト ビッグカーニバル

キョーリンクオリティ
キョーリン宇宙への挑戦
-

-
無重力の宇宙空間でメダカを飼育するためには、特別な飼育設備と設備に合わせた専用の宇宙食が必要となります。宇宙開発事業団から依頼されて、世界で初めてとなるメダカ用宇宙食の製造を請け負ったのが弊社です。・・・詳細を見る
キョーリンのご案内
-

-
観賞魚の養殖・輸入から飼料の開発・製造・国内外への販売。そしてあらゆる飼育・観賞環境の創造にいたるまで。 「“生き物”を扱うからには、その“食生活”はもちろん、“生活環境”のすべてにベストな提案をしたい」というのが、私たちの基本理念です。 ・・・詳細を見る
山崎研究所について
-

-
アクアリウムを科学的に分析、『観賞魚をより美しく、より健康的に楽しむために』新しい価値を創造し、これまで世界になかった商品を生み出します。 ・・・詳細を見る
キョーリンの工場について
-

-
世界的なペットフードの製造基準はどんどん厳しくなっています。厳しいEUの審査基準をクリアしているキョーリンだからこその、高い品質管理と衛生管理がコンセプトです。 ・・・詳細を見る
カミハタ探検隊
-

-
カミハタは、通称「カミハタ探検隊」と呼ばれる調査活動をおこなってきた。神畑会長を隊長に、毎年世界的な冒険家や研究家、そしてカミハタの若手社員たちがチームを組んで秘境へと出かけていたのです。 ・・・詳細を見る
商品一覧
- 新商品ランナップ
- 錦鯉用飼料
- 金魚用飼料
- 熱帯魚用飼料
- 咲ひかり
- メダカ・川魚用飼料
- 海水魚用飼料
- 冷凍・天然飼料
- 両生類・爬虫類用飼料
- 小動物用飼料
- 鳥用飼料
- その他飼料
- 観賞魚用器具類・薬品
- 商品一覧から探す
- 販売終了商品(2005~)